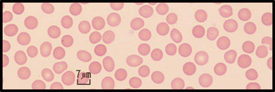
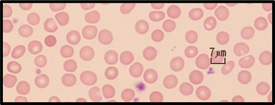

-貧血と多血-
| 東区・郡元支部 (デイジークリニック) 武元 良整 |
|---|
はじめに
同じ日に「多血を指摘された10歳代後半の女性」と「貧血を指摘された30歳代女性」の来院がありました。その2例ともに低フェリチンでした。なぜでしょうか?その2症例を提示いたします。
症例 1
10歳代後半の女性。事務職。
主訴:多血の再検査希望(赤血球数 522万/μL,血色素:14.4g/dL,ヘマトクリット44.3%)
病歴:自覚症状なし。貧血治療は受けたことがない。
背景:身長158cm,体重48.0kg,BMI:19.2。
運動歴:中学でソフトテニス3年間。
来院時検査成績
末梢血CBC:全血算(complete blood count)は以下です。
| RBC:469万/μL,Hb:13.6g/dL,Ht:40.3%,MCV (mean corpuscular volume:平均赤血球容積):85.9fL,MCH(mean corpuscular hemoglobin:平均赤血球血色素値):29.0pg,PLT(血小板数):26.3万/μL |
| 血清鉄:39μg/dL(基準値40-158μg/dL),フェリチン:5.8ng/mL,(12.0以下は鉄欠乏:WHO基準) |
検査診断:赤血球数は正常。血色素正常,低フェリチンの所見から典型的な「潜在性の鉄欠乏状態」と診断1)。MCVが85.9と低下。その正常値は90.02)。赤血球数が522万の原因は健診当日,絶飲食,脱水高度。鉄欠乏状態を補う代償性赤血球増加があったのではと推定します。
末梢血血液像:図1に小球性低色素性の赤血球(鉄欠乏)と正球性正色素性赤血球とが混在しています。
臨床診断:潜在性の鉄欠乏状態。
|
| 図 1 (末梢血液画像は鹿児島市医師会臨床検査センター 血液検査室へ依頼し撮影いただきました) |
治療:治療はまず,食事指導。「女性に大敵」の貧血を食事面から予防する事を目指しています(図2)。「KAGO食スポーツ」とは健全なアスリート育成の一環として食事指導に力を入れている組織です3)。中高生から社会人まで貧血の個別栄養指導をお願いしております。貧血原因となるような消化器・婦人科的疾患がなければ,食事は鉄分摂取を意識して1カ月ごとに施行する末梢血検査でMCVなどの改善を観察する予定です。
 |
| 図2 |
症例 2
30歳後半,女性。荷物運搬等。
主訴:長年の貧血あり。
現病歴:健診で常に貧血指摘。鉄剤内服困難でいつも治療継続できず。乗り物酔い,たちくらみ,肩こり,頭痛がある,最近では息切れ,手指のしびれもある。
背景:5歳,9歳育児中。2人の妊娠中も貧血,胃内視鏡正常。婦人科でも正常。ピル内服したことはない。喫煙歴なし,非飲酒。身長154cm,体重52.7kg,BMI:22.2。
運動:学生時代は陸上部とバスケットボ-ル部。最近まで,ジョギングを時々。
検査成績
| RBC:475万/μL,Hb:8.9g/dL,Ht:28.0%,MCV:61.1fL,MCH:18.7pg,PLT:32.1万/μL |
| 血清鉄:8μg/dL,フェリチン:4.3ng/mL |
検査診断:小球性低色素性の典型的な鉄欠乏性貧血。
末梢血血液像:明らかな赤血球の大小不同2+あり,多染性1+あり。
|
| 図 3 (末梢血液画像は鹿児島市医師会臨床検査センター 血液検査室へ依頼し撮影いただきました) |
臨床診断:典型的な鉄欠乏性貧血。
治療:遠方から通院のため,鉄欠乏性貧血に有効とされる漢方治療(当帰芍薬散)を開始。
まとめ
赤血球増加(522万)の症例1は精密検査により潜在性鉄欠乏(低フェリチン:5.8)と診断できました。症例2は典型的な鉄欠乏性貧血です。赤血球数の値から判断すれば貧血と言えない場合があります。
最後に,図2の「女性に大敵/貧血予防」という言葉の医学的根拠は貧血の症状がなく「低フェリチン」の女性が多く,必ずしもHbが低値とならないことを示しています。
文 献
1. 日本鉄バイオサイエンス学会 治療指針作成委員会編:鉄剤の適正使用による貧血治療指針 第3版. 響文社,札幌. 2015
2. Rapaport SI Introduction to Hematology second edition, JB Lippincott Company 1987.
3. http://kg-sport.com/company/
(C)Kagoshima City Medical Association 2018